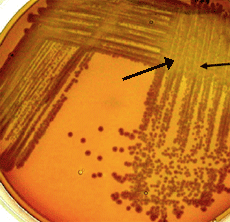
See vacant positions created by lysis of former lab members....are you sure you're up for this?

School of Biosciences & Biotechnology, |
| Vacancies |
| Qualified candidates for the posts below are invited to apply by phone or email for an interview. 1. Post-doctoral research fellows 2. Research assistants and post-graduate students (MSc and PhD programmes) Qualification requirements - Post-doctoral researcher: PhD or equivalent in any of the following (but not restricted to) fields: Biochemistry/Molecular Biology/Genetics, Physics, Chemistry, Mathematics, Computer Science, Computational Sciences, Information Science. Qualification requirements - MSc Programme: BSc (Biochemistry/Molecular Biology/Genetics, Physics, Chemistry, Mathematics) or BSc (Computer Science, Computational Sciences, Information Science) from a university recognized by Universiti Kebangsaan Malaysia with a minimum CGPA or equivalent of 3.2. Research Assistants: As for the MSc programme above. RAs applying for the post of IT Technician require a minimum of a relevant Diploma in Information Technology. Qualification requirements - PhD Programme: MSc or BSc (1st class Hons) from a university recognized by Universiti Kebangsaan Malaysia in a relevant field or as listed for the MSc programe above. Notes: Non Malaysian applicants for whom English is not the native language are required to provide documentation of English proficiency (IELTS - Band 6.5 and above or equivalent) in addition to satisfying the requirements for entry into the Universiti Kebangsaan Malaysia graduate programme. |
Last updated: September 2012